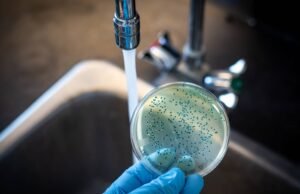
RD ya suma 47 casos de cólera, reportan cuatro nuevos contagios

Redacción
Lluvias débiles y temperaturas agradables para hoy, prevé Onamet
Tiempo.- El estado de tiempo estará dominado por un sistema de alta presión, limitando el contenido de humedad en la masa de aire que...
México y Estados Unidos deportan a más de 196.300 centroamericanos en...
Internacionales.- Las autoridades de México y Estados Unidos deportaron a más de 196.300 salvadoreños, guatemaltecos y hondureños en 2022, entre ellos más de 35.000...
Pavel Núñez inicia su gira 2023 con presentaciones en RD y...
Espectáculos.- Pavel Núñez sigue siendo el más activo promotor de la música melódica del país y lo evidencia su permanente ciclo de presentaciones en República...
Tom Brady anuncia su retiro definitivo del fútbol americano
Deportes.- Las razones por las que Tom Brady se enamoró del fútbol americano están en San Francisco, California, y tienen nombre y apellido: Joe...
Gobierno realizará levantamiento más exhaustivo para verificar daños del temblor
Santo Domingo.- El ministro Administrativo de la Presidencia, José Ignacio Paliza, que se realizará un levantamiento más exhaustivo tras el temblor de 5.3 grados...
RD ya suma 47 casos de cólera, reportan cuatro nuevos contagios
Santo Domingo.- El Ministerio de Salud Pública notificó este miércoles cuatro nuevos casos de cólera, aumentando a 47 el total de contagiados de la...
Pro Consumidor implementa moderna plataforma tecnológica para agilizar reclamaciones
Tecnología.- El Instituto Nacional de Protección de los Derechos del Consumidor (Pro Consumidor) pondrá en funcionamiento una nueva plataforma digital al servicio de los...
COE activa plan de contingencia contra terremotos
Santo Domingo.- El Centro de Operaciones de Emergencia (COE) activó su plan de contingencias contra terremotos, tras el temblor de tierra de 5.3 grados...
Miguel Vargas llama la atención sobre necesidad de apoyar la juventud...
Política.- El ingeniero Miguel Vargas Maldonado expresó su preocupación en torno a los permanentes desafíos que enfrenta la juventud dominicana, en especial la emprendedora,...
Pronostican nublados desde horas matutinas con chubascos aislados
Tiempo.- Un sistema de alta presión continuará este miércoles dominando las condiciones atmosféricas sobre el territorio nacional, con un ambiente de nubes dispersas y...